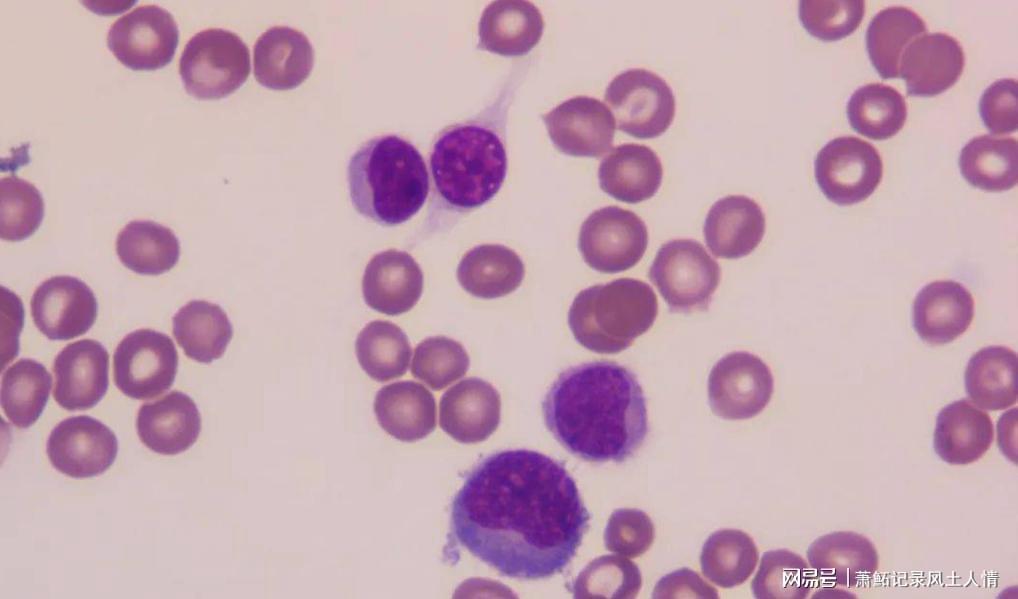

王阿姨今年62岁,退休后的日子本该轻松自在。命运在她48岁那年悄然转弯——乳腺癌的诊断像一道闷雷,击碎了她和家人的平静生活。
经历了手术、化疗的折磨,原以为一切会慢慢恢复。没想到,5年后肿瘤复发,并在3年内又发生了2次转移。那段时间,她一度以为自己就此走到了人生尽头。
可让身边人意外的是,王阿姨并没有被病魔彻底击垮,她说:“每天醒来,我都告诉自己——只要还活着,就还有希望。”也正是这句简单的话,成了她走过20年抗癌路的动力。如今的王阿姨,身心状态稳健,随访已超过5年未复发,成了邻里间口口相传的“抗癌传奇”。很多人好奇:她到底做对了什么?难道癌症康复,真的和心态、生活方式有关?
你可能以为,完全战胜癌症,只能靠先进技术和昂贵药物。但越来越多的权威研究发现,积极的心态和科学的生活调整,往往比外界想象的更强大。王阿姨的一句话背后,究竟藏着哪些医学道理和科学支撑?今天,我们就来聊聊,“抗癌成功”的可能性,究竟还欠缺哪些细节?
医学界公认,癌症的发生与多个因素相关,包括遗传、环境、生活方式以及心理状态。中国医科大学附属第一医院肿瘤科的公开数据显示,情绪状态能影响患者免疫力,直接作用于康复进程。美国哈佛大学的研究团队追踪1600名癌症患者,发现坚持心理疏导、保持正面心态者,5年生存率提升了约18.7%。

王阿姨在分享自己的经历时坦言,“癌症确实令人恐惧,但如果每天都活在焦虑和恐慌中,身体反而更容易垮掉。”国家癌症中心的调研也证实,长期焦虑、失眠等负面情绪会导致应激激素升高,抑制免疫细胞活性,进而影响肿瘤细胞清除和修复。
除了心理因素,合理的饮食、规律运动、科学治疗管理,也是癌症长期生存的关键。2019年中华医学会肿瘤分会指南明确指出,高蛋白、低糖、多蔬果饮食模式能显著降低术后复发风险。在王阿姨的日常生活中,她每日坚持6000步的慢走(约40-50分钟),饮食选择上以豆类、全谷、深色蔬菜为主,同时调整作息、避免熬夜——这些点滴小事,成为她抗癌路上的“护身符”。
坚持心理自我调节和科学生活习惯多年后,王阿姨身体出现了以下显著变化,这些正是权威研究高度肯定的“抗癌指标”:
免疫力明显改善。根据她历年体检数据,外周血中淋巴细胞比率从治疗初期的18%提升至24%(正常成年人平均水平在20-35%之间),这被认为与免疫监控能力增强密切相关。
精神状态整体好转。王阿姨分享:“以前始终不安,现在每天都能睡7小时。”哈佛团队研究也提示,每晚保证7-8小时睡眠,肿瘤患者复发率或可降低12.5%-17%。
生活质量稳步提升。过去常因化疗后不适感焦虑,每天待在家里等病情消息。如今,她会主动参加社区志愿服务,与朋友户外踏青、聊天,自评幸福感提升3倍以上,心理健康量表得分在70分以上(远超同龄患者平均线)。
复发风险持续降低。跟踪影像学记录显示,她过去5年内无局部及远处复发。按北京协和医院肿瘤随访数据,仅有约9.7%的同龄同型患者能实现这一“无复发5年”目标,“一念之间”的坚持或许就是那关键的分水岭。
很多人认为,积极的心态听起来像“鸡汤”。但国内外大样本研究已经证实,心态和行为的微小改变,可以对癌症康复产生实打实的生理影响。想要如王阿姨一样,走出困境,医生建议重点做到以下3点:
一是学会心理应激管理。无论面临怎样的诊断结果,都要学会“消化情绪”。可以尝试记录心情日记、与信任的家人朋友倾诉,或加入支持团体。必要时咨询肿瘤心理科医生,配合正念冥想、呼吸训练,每日10~20分钟,即可明显改善焦虑和压力。
二是合理安排饮食运动。遵循“多样出彩,均衡至上”。每日摄入15-20克蛋白质,优选鱼、豆、蛋;新鲜蔬菜水果保证7种色彩入餐盘。避免高糖高油;饭后慢步可帮助促进消化和稳定血糖。有条件可定期营养师随访,优化摄入结构。
三是坚持规范治疗与复查。不要任性停药或跟风偏方,所有治疗调整都应听取专科医生意见。定期复查,密切关注自己身体的微小变化,疑问随时与主治医生沟通。

抗癌路上,没有一种“万能法”,但每一天的选择都关乎结局。王阿姨的“一句话”,或许正是无数患者走在康复路上的精神注脚。健康其实就藏在每一天的理性选择和积极心态里。


































热门跟贴